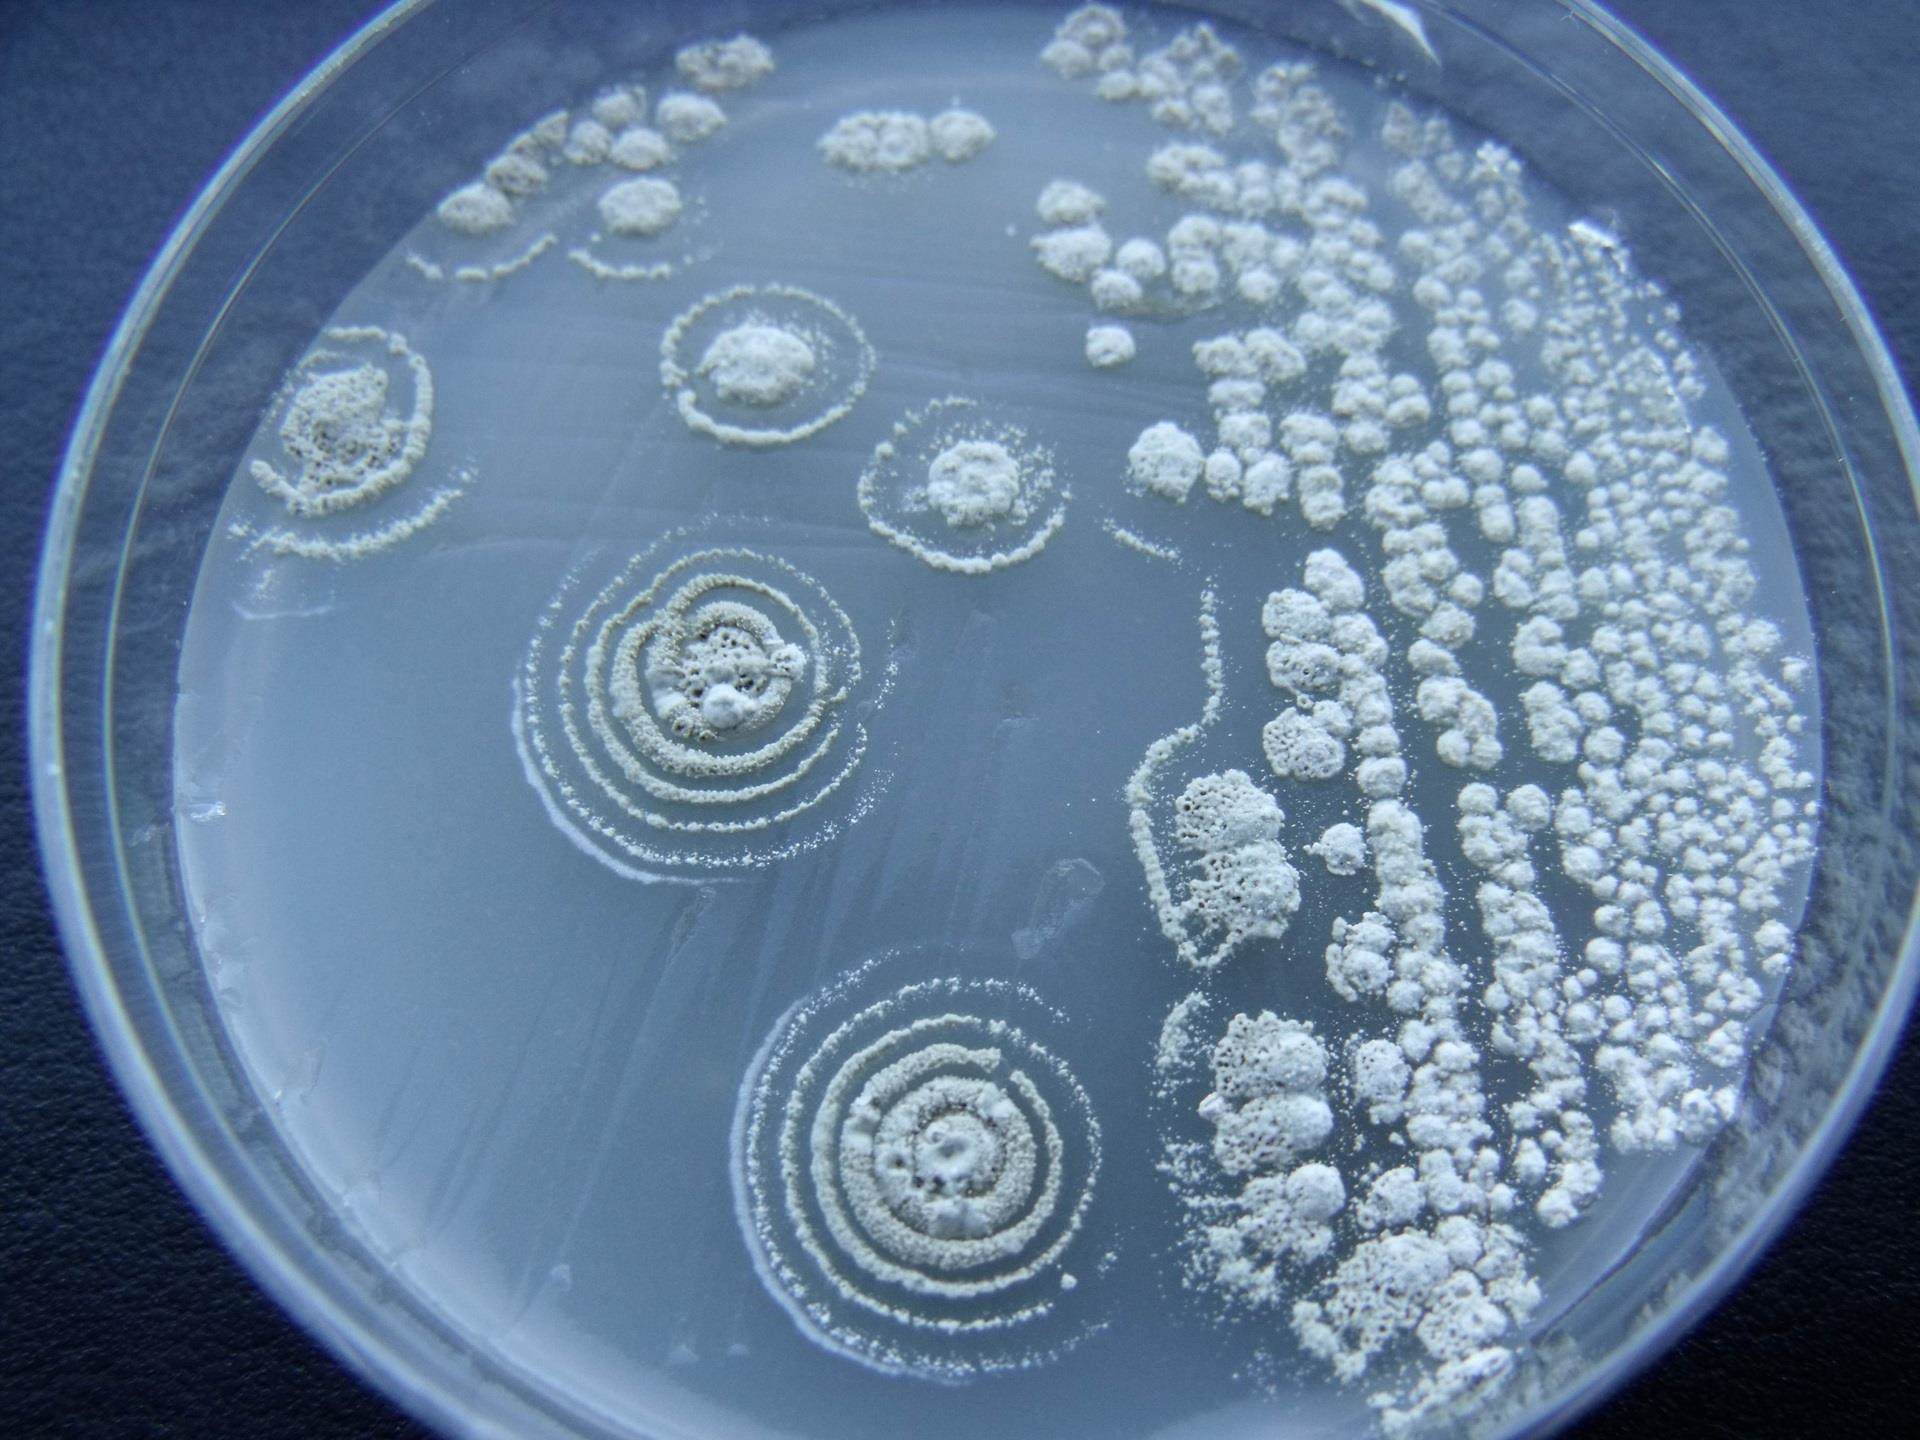
Nautilus Bioscience

Croda acquires marine biotechnology specialists Nautilus
11 January 2018: Croda International Plc, who create, make and sell speciality chemicals for some of the biggest, most successful brands in the world, today announced that it has acquired Nautilus Biosciences Canada Inc (‘Nautilus’), a technology-rich marine biotechnology company based in Charlottetown, Prince Edward Island, Canada.
Nautilus was founded in 2007 by Professor Russell Kerr and, together with its world class scientists, focuses on using marine microbial biodiversity to discover novel actives and materials. Through this acquisition and the associated patents, Croda will utilise this innovative science for applications across all its market sectors.
Croda and Nautilus already have a proven history of successful collaboration, having worked closely together for the past six years developing specific applications for skin care and hair care, as well as crop care. Croda intends to establish Nautilus as a Croda Centre of Innovation for Marine Biotechnology at Nautilus’ existing base at the University of Prince Edward Island. This location is ideal for biotechnology research and has already attracted and facilitated partnerships with many other biotechnology-based companies. Nautilus has exclusive global access to the Marine Microbial Library which is based at the University of Prince Edward Island.
Steve Foots, Chief Executive of Croda, said: “This is another clear example of how sustainable innovation is underpinning our growth plans. With Nautilus as part of the Croda Group, we further expand our expertise in biotechnology; the Nautilus team that will join us have extensive knowledge and expertise in marine biotechnology, also known as “blue biotechnology”. We will be able to bring new, patented products to market, alongside our already well-known green and white biotechnology ingredients, giving us the full spectrum of capabilities within this field of science.”
Professor Russell Kerr, Founder of Nautilus, said: “We have enjoyed a very positive and collaborative relationship with both Croda and the University of Prince Edward Island for a number of years and have always been impressed with Croda’s drive to develop the opportunities from marine biotechnology. Becoming part of the Croda group will provide Nautilus the resources and support to establish a key centre for the research and development of marine-derived natural products, as well as providing Croda new products for commercial success.”
Alaa Abd-El-Aziz President and Vice-Chancellor of The University of Prince Edward Island, said: “We are delighted that a technology rich enterprise coming from the University will become part of an internationally recognised company like Croda, and that their excellent work researching marine microbial microbiology will continue to develop and have commercial realisation. We look forward to future opportunities for partnership and collaboration with both Nautilus and Croda.”